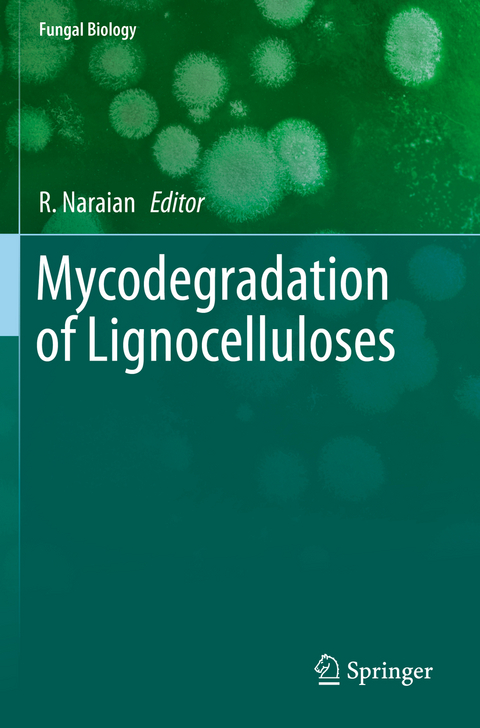
Mycodegradation of Lignocelluloses -

Mycodegradation of Lignocelluloses
Springer International Publishing (Verlag)
978-3-030-23836-0 (ISBN)
This book provides a knowledge-based view to the dynamic capabilities in an organization. The author integrates two existing views on gaining competitive advantage: the Knowledge View which suggests that the capability of organizations to learn faster than competitors is the only source of competitiveness; and the Dynamic Capability View which speculates that a fi rm's competitive advantage rests on it's ability to adapt to changes in the business environment. Using the IT sector in India as a case study, this book provides and tests a new framework-Knowledge-Based Dynamic Capabilities-in the prediction of competitive advantage in organizations.
Dr. Ram NaraianDepartment of Biotechnology, Faculty of SciencesVeer Bahadur Singh Purvanchal University, Jaunpur, (Uttar Pradesh) India
ramnarain_itrc@rediffmail.com
+91-9453095777
Preface.- Compositional biochemistry of lignocellulosic resources and an overview of their Mycodegradation.- Basic principle and mechanism of lignocellulosic Mycodegradation.- Efficient fungal enzyme system working in mycodegradation of lingo celluloses.- Fungal biodiversity producing cellulose involved in efficient cellulolysis.- Fungal biodiversity producing laccase and peroxidase involved in efficient ligninolysis.- Fungal biodiversity producing enzymes involved in efficient xylanolysis.- Fungal cellulase system and mechanism of cellulolysis during Mycodegradation.- Fungal pectinase system and mechanism of pectinolysis during Mycodegradation.- Strategic role of lactases during mycodegradation of lignocelluloses.- Application of mycodegradation in mushroom production. Selective mycodegradation of lignin in paper and pulp industry.- Mycodegradation and bioconversion of lignocelluloses into bioactive compounds.- Fungal digestion/treatment of lignocelluloses for nutritious animal fodder.- Fungal hydrolysis and saccharification of lignocellulosic wastes for bioethanol production.- Application of mycodegradation in production of secondary metabolites.- Mycodegradation of lignocelluloses and release of common metabolites.- Multiple factors influencing the strategy of Mycodegradation.- Bioconversion of lignocelluloses into nutrient rich Agaricus mushroom.- Index.
| Erscheinungsdatum | 30.10.2020 |
|---|---|
| Reihe/Serie | Fungal Biology |
| Zusatzinfo | VIII, 252 p. 30 illus., 20 illus. in color. |
| Verlagsort | Cham |
| Sprache | englisch |
| Maße | 155 x 235 mm |
| Gewicht | 403 g |
| Themenwelt | Naturwissenschaften ► Biologie ► Genetik / Molekularbiologie |
| Naturwissenschaften ► Biologie ► Mikrobiologie / Immunologie | |
| Naturwissenschaften ► Biologie ► Mykologie | |
| Schlagworte | bioconversion • biodegradation • enzymes • fungal biology • Lignocelluloses • Lignocelluloytic enzymes • Mycodegradation • systematic botany |
| ISBN-10 | 3-030-23836-9 / 3030238369 |
| ISBN-13 | 978-3-030-23836-0 / 9783030238360 |
| Zustand | Neuware |
| Informationen gemäß Produktsicherheitsverordnung (GPSR) | |
| Haben Sie eine Frage zum Produkt? |
aus dem Bereich


